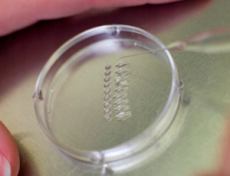
Defectos del tubo neural

Complicaciones del embarazo
La mayoría de los problemas gestacionales tiene tratamiento
Las complicaciones del embarazo pueden ser muchas pero hay una buena noticia: la gran mayoría tiene tratamiento. Puede existir una enfermedad materna anterior, una patología que surja al hilo del embarazo, complicaciones de la placenta, del desarrollo del bebé… Nuestro consejo: déjate asesorar por tu ginecólogo, sigue el tratamiento y mantén una actitud positiva ante las dificultades.
No se puede predecir qué gestantes con miastenia gravis empeorarán durante los meses del embarazo. Tampoco se puede saber qué recién nacidos manifestarán ciertos síntomas (llanto leve, dificultad para tragar...). Lo que sí se puede (y se debe) hacer antes de la concepción es consultar a un...
¿Embarazada con lupus? Es posible
Cada día hay más mujeres que se quedan embarazadas con enfermedades crónicas como lupus eritematoso. Es básico consultar al ginecólogo antes de la concepción del bebé y llevar un estrecho seguimiento de la gestación, que estará considerada de alto riesgo. La mayoría de las madres logra un...
Preeclampsia y eclampsia, a examen
Se trata de dos enfermedades que solo se dan en el embarazo, muy peligrosas, tanto para la madre como para el feto. El principal síntoma es la tensión alta, pero no es el único. Te detallamos cuáles son los signos, señales y síntomas de preeclampsia y eclampsia (la complicación más grave)...
Preeclampsia, sus primeros síntomas
La preeclampsia es una enfermedad del embarazo. Supone una complicación grave que aparece a partir de las 20 semanas de gestación. Por si no lo sabías, en algunas ocasiones puede aparecer después de nacer el bebé, en el transcurso de las primeras 48 horas posparto. Te explicamos cómo...
Legrado, ¿por qué se realiza?
Cuando una mujer sufre un aborto espontáneo en los primeros tres meses de embarazo es frecuente que el médico realice un legrado para extraer el embrión. Así el útero se prepara para el siguiente embarazo. Seguramente has oído en más de una ocasión que a una amiga, conocida o familiar...
Signos de depresión en tu embarazo
A menudo es difícil saber si tienes una depresión en el embarazo, y cómo salir de ese estado. Si te sientes triste, sin ganas de nada o te asaltan pensamientos negativos puedes estar ante una depresión. No son síntomas del embarazo y por eso es recomendable acudir al médico porque puede...
Sustancias dañinas para el bebé
Un teratógeno es cualquier sustancia química, agente físico (radiaciones), infeccioso, enfermedad materna o estado carencial que, cuando actúa en el embrión o feto, puede alterar de forma grave el crecimiento o desarrollo intrauterino del bebé. Estas sustancias son capaces de producir...
Defectos del tubo neural
Este tipo de malformaciones consisten en alteraciones en la columna vertebral y otras estructuras músculo-esqueléticas que tienen como principal función la protección del sistema nervioso central que se encuentra en su interior. Como su nombre indica, se originan al principio del embarazo...